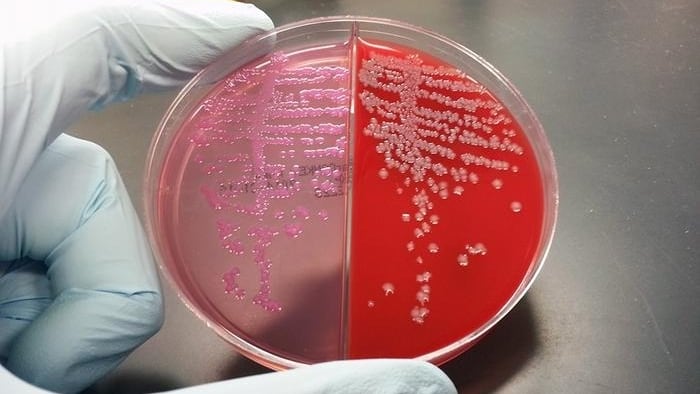
El análisis del microbioma canino utilizó secuenciación del gen 16S rRNA y detectó 899 variantes bacterianas en 51 perros./Archivo Sokurenko Lab/UW Medicine

Un grupo de bacterias en el intestino de los perros que desarrollan cáncer puede influir en el resultado del tratamiento con inmunoterapia.
Así lo reveló una investigación que fue publicada en la revista Veterinary Oncology. Identificaron que once tipos de bacterias intestinales pueden estar asociadas a la supervivencia de perros tratados con inmunoterapia.
La investigación estuvo a cargo de Richard Rodrigues y Vini Karumuru, del Laboratorio de Inmunología Integrativa del Cáncer en el Instituto Nacional del Cáncer de los Estados Unidos, junto a Natalia Shulzhenko, de la Universidad del Estado de Oregón y colaboradores.
Tras hacer el estudio, los investigadores resaltaron que esas asociaciones identificadas permanecieron significativas después de ajustar por factores como el diagnóstico de hemangiosarcoma (un tipo de cáncer que se origina en los vasos sanguíneos) y la edad avanzada.
Además, destacaron que es el primer estudio en identificar firmas microbianas intestinales vinculadas a la supervivencia en perros sometidos a inmunoterapia contra el cáncer.
Las firmas microbianas son el conjunto específico y único de microorganismos que habitan un entorno, individuo o parte del cuerpo.
“Los resultados del estudio son interesantes para conocer más sobre microbiomas y la relación con tumores. Sin embargo, considero que aún faltan más investigaciones que corroboren los hallazgos del trabajo publicado en Veterinary Oncology”, opinó Andrea Llera, investigadora en oncología molecular del Conicet en la Fundación Instituto Leloir.
Microbioma, inmunidad y cáncer

El cáncer es la principal causa de muerte en los perros. El uso de inmunoterapia, que cambió la medicina humana, empieza a generar expectativas para el tratamiento de esos animales.
En los últimos años, se probaron vacunas dirigidas a proteínas como EGFR y HER2 como inmunoterapias, pero faltaba comprender cómo la microbiota intestinal influye en los resultados.
En medicina humana, ya se había demostrado que la composición del microbioma puede potenciar o limitar el éxito de la inmunoterapia.
Por eso, el equipo de investigadores intentó averiguar si algo similar ocurría en perros y si ciertos microbios podían predecir el tiempo de vida tras el tratamiento.
Para comprobar esta hipótesis, el equipo diseñó un estudio con perros de distintas razas y tipos de cáncer, analizando su microbioma antes de iniciar el tratamiento.
Búsqueda bacteriana: cómo se hizo el estudio

Participaron 51 perros atendidos en el Centro de Referencia Animal Bridge de Estados Unidos. Los investigadores tomaron muestras rectales antes de la primera vacuna, siempre con el consentimiento de los responsables de los animales.
El estudio del ADN bacteriano se realizó con técnicas de secuenciación del gen 16S rRNA, que permite detectar qué microbios están presentes. En promedio, cada muestra aportó 32.262 secuencias y se detectaron 899 variantes bacterianas.
El análisis demostró que no había diferencias en el microbioma según sexo, raza o tipo de cáncer, lo que muestra que la composición bacteriana era diversa y no estaba sesgada en el grupo estudiado.

Luego, mediante análisis estadísticos, se identificaron las once bacterias asociadas a la supervivencia: siete ligadas a mayor riesgo de muerte y cuatro a una supervivencia más larga. Estas relaciones se mantuvieron incluso cuando se consideraron factores como el hemangiosarcoma o la edad avanzada.
“Los resultados resaltan el papel de los microbios como posibles biomarcadores específicos de inmunoterapia”, escribieron los científicos.
Nuevos horizontes y desafíos

De acuerdo con los investigadores que el próximo paso de la investigación debería ser la ampliación de la muestra para validar los resultados en grupos más grandes.
También señalaron que faltó información sobre la dieta de los perros, un dato que puede influir en el microbioma bacteriano. El tamaño reducido del grupo limita la generalización de los hallazgos.
No pudieron determinar si las bacterias detectadas son marcadores generales de supervivencia al cáncer o si son específicas de la inmunoterapia. Sugirieron que se debería probar el trasplante de microbiota o el uso de probióticos en ensayos clínicos.
Sin embargo, pese a las limitaciones del trabajo, los científicos destacaron que las once bacterias identificadas abren la puerta a la medicina personalizada en oncología veterinaria.

“Nuestro estudio es un primer paso para usar el microbioma intestinal como una herramienta para desarrollar pronósticos y manipular el cáncer, no solo en perros, sino potencialmente también como modelo para tratamientos humanos”, afirmó la doctora Shulzhenko, quien estudia las interacciones entre el huésped y la microbiota en la Universidad Estatal de Oregón.
Esta investigación, así como el tratamiento inmunoterapéutico en general, se encuentran en etapas muy iniciales, pero los hallazgos sugieren que tratamientos microbianos como los probióticos o los trasplantes fecales podrían complementar la vacuna contra el cáncer canino, de acuerdo con la investigadora.
“En el futuro, un análisis de un hisopado del microbioma podría ayudar a predecir qué tan bien responderá un perro a un tratamiento contra el cáncer”, subrayó.






